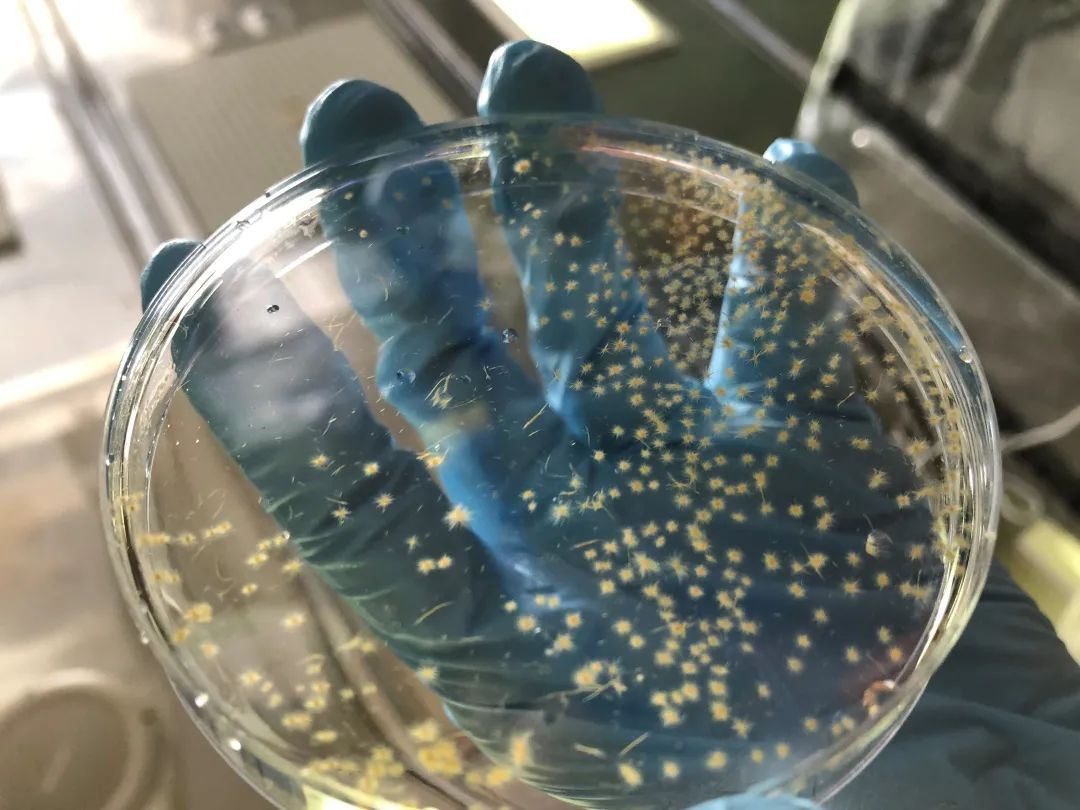

你知道吗?你此刻呼吸的空气,约78%由氮气组成,可氮气的化学性质很不活泼,几乎无法被生物利用。不过,有这样一群“雷锋”,它们拥有“点石成金”的能力,能把氮气转化为生物可利用的氮营养盐,从而造福其他生物。它们的名字叫作“固氮生物”,它们固氮的过程叫作“生物固氮作用”。
在广阔的海洋里是否有固氮生物?
它们在全球海洋的分布格局如何?
生物固氮作用的机理是什么?
受到哪些因子的调控?
……
如今,关于生物固氮,还有无数谜团正等待着科学家们解开。厦门大学近海海洋环境科学国家重点实验室的史大林教授课题组就是这“解谜团”中的一员。
今年2月,近海海洋环境科学国家重点实验室史大林教授课题组与国内外合作者在Science Advances发表了题为Nutrient regulation of biological nitrogen fixation across the tropical western North Pacific的研究论文,揭示了铁和氮供给比率(Fe:N supply ratio)是调控热带和亚热带西北太平洋生物固氮的重要因子,为全球海洋尺度上认识海洋生物固氮的时空格局及其调控机理提供了重要的观测和理论依据。
去海上,解谜
论文第一作者,厦门大学博士后温作柱介绍道:“开阔的大洋就像一片贫瘠的土壤,营养物质极度匮乏,生活在大洋里的浮游植物一直都是‘饿着肚子’的。”
在海洋浮游植物中,固氮生物仅占非常小的一部分,虽然少,但它很重要。因为它可以通过体内的固氮酶,将氮气转化为生物可利用的氮营养盐,从而给自己和其他浮游植物提供营养。据估算,固氮生物可贡献高达50%的海洋外源生物可利用氮。
固氮生物——束毛藻
有了固氮生物“施肥”,其他浮游植物便可获得养分执行光合作用、吸收大气中的二氧化碳,从而调节全球气候。
也就是说,如“蝴蝶效应”一般,生物固氮作用最终对调节全球气候,可能具有重要作用。
在全球热带、副热带海域,生物固氮作用普遍存在,但它的时空格局如何?调控因子又是什么?这些成为了史大林团队致力破解的“谜题”。

史大林在“嘉庚”号上
“我们从2013年就开始做海洋现场观测的工作了”史大林表示,“现场观测与实验室研究相辅相成,是我们团队的传统。”秉持着这样的研究理念,多年来,团队始终坚持去到现场开展生物固氮的研究。
为此,团队学生里的“老大哥”温作柱前后参与了十几个科考航次,共计在海上待了300多天。“我有连续三年的生日都是在海上过的,也在海上给很多人过过生日。”他笑着说。

温作柱在科考船上
海上的实验室
所谓“痕量”,指的是极小的量,“少得只有一点痕迹”。
在海洋中,一些痕量金属(例如铁)的浓度往往低于1nmol/L。研究对象越是精细、浓度越低,对实验环境、技术的要求就越高。即便到如今,全世界能做痕量金属实验的实验室也屈指可数。
“在痕量级别的条件下,哪怕一点点的污染,比如人走过去或哈个气,就可能破坏实验培养体系。”为了做痕量金属研究,2012年,博士毕业、回国任教的史大林和妻子洪海征决定,要在厦大建一个达到国际最高标准的“洁净实验室”。

课题组学生在痕量金属洁净实验室做实验
这里的“洁净”,并非通俗意义上的“干净”,而是要求空气中金属颗粒的含量足够低。因此,在这间实验室里,所有的东西都得尽量使用非金属材质:塑料实验台,塑料灯罩,就连螺丝钉也得是塑料的。此外,实验室还需要一台全年无休的机器过滤空气,将金属颗粒挡在门外。
于是两个初出茅庐的年轻学者,在科研经费上精打细算,其他研究“只花保证研究的钱”。2014年,这间特别的“洁净实验室”在翔安校区建成。
实验楼里有洁净实验室还不够,团队很快开始尝试将洁净实验室“搬”到海上,建立海上“痕量金属洁净实验台”和痕量金属洁净海水采集系统—“飞鱼拖体”。为了模拟自然的光照条件,由“飞鱼”采集的洁净海水在“痕量金属洁净实验台”上进行实验处理后,装入密封的洁净培养体系,又返回露天、颠簸的甲板培养系统进行培养。
在一次次“test”,一次次“污染”,一次次失败中……海上的“痕量金属洁净实验室”终于诞生了。

出海用的痕量金属洁净实验室外部(左)、内部(右)

甲板培养系统
在建立开展现场痕量金属研究需要的一系列装备后,史大林团队和合作者对包括南海北部海盆在内的热带西北太平洋海区的固氮速率和固氮生物群落开展了大尺度、高分辨率的观测。并在进一步研究中发现,真光层中铁和氮的供给比率,是调控生物固氮空间格局的重要因子。
“就像刚才说的那样,大洋是很贫瘠的,虽然固氮生物不缺氮,但它们和其他生物一样,也缺铁和磷。”温作柱介绍道。其中,“铁”是固氮作用中不可或缺的辅酶因子,当铁含量比较高时,本就不缺氮的固氮生物拥有了更强的生长优势,从而消耗环境中本就缺乏的磷,限制其他生物生长。
就在这“此消彼长”的竞争关系中,生物固氮的总体效能也随之改变。

西北太平洋生物固氮的营养盐限制特征

Fe:N supply ratio对西北太平洋固氮作用的调控
该项研究系统阐明了西北太平洋从边缘海到开阔大洋的固氮速率和固氮生物的空间格局,发现固氮速率和固氮生物丰度与硝酸盐跃层深度以及Fe:N比值显著相关,并首次揭示了西北太平洋固氮作用的铁、磷营养盐限制及其空间变异性,填补了该研究领域的空白。
向海,向洋,向未来
在史大林看来,“合作”一词贯穿了该项研究的全过程。
在开展甲板受控培养实验时,每个培养体系需要10升以上的海水,再加上不同的海水层位、实验处理……每次实验需要搬运上百升的海水。除了体力的巨大消耗,实验的开展还要求科研人员时刻保持清醒的头脑,一旦弄乱弄脏了其中一个样品,可能一系列的样品都得作废。
因此,史大林团队的每位成员,都已养成了“并肩作战”的习惯。“无论是谁的实验,其他人都会前来帮忙。”

2017年,史大林(左二)和学生们在“嘉庚号”上,照片拍摄当天是史大林40岁的生日
“同时,该项研究也离不开《国家自然科学基金重大项目—CARBON-FE》和《国家重点研发计划项目—MARCO》项目团队的支持。”
其中,厦大戴民汉院士团队、蔡毅华教授团队以及上海交通大学张瑞峰副教授团队等分别承担了营养盐和痕量金属铁浓度等参数的测定工作,提供了珍贵的配套数据。德国GEOMAR亥姆霍兹基尔海洋研究中心 Thomas Browning博士也为航次数据分析、理论框架搭建以及论文撰写等提供重要的帮助。
温作柱表示,“这项成果是大家一起完成的,仅凭我们一个团队的力量是远远不够的。”
“未来,我们还会坚持现场观测的工作,研究的范围也会渐渐从南海扩大到太平洋,再到全球海域。碳、氮及痕量金属生物地球化学循环与全球变化,始终是我们最关注的课题。”他们说。
从厦园里的一间实验室,到大洋上的一个实验台。这群厦大人从不放过眼底“一尘”,也从未忘记把目光投向世界。
科研的舞台越来越大,他们也将继续向海,向洋,向未来!
(文/曾文萃 图/受访者提供)